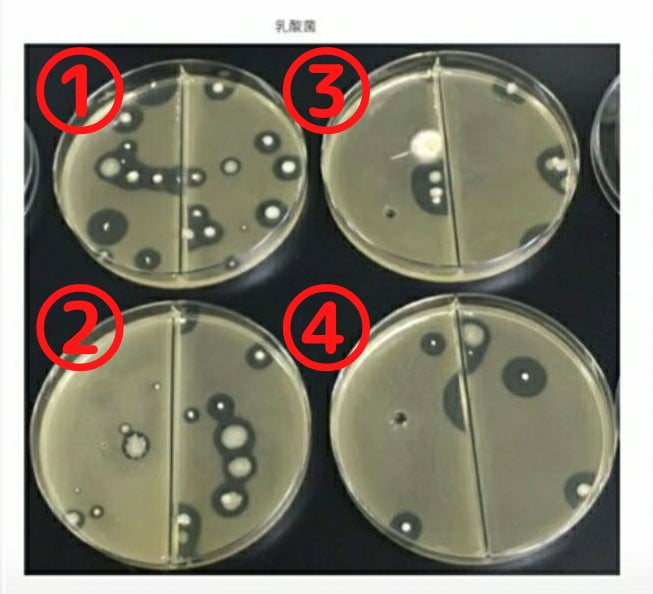

こんにちは!れあくらぼ北海道株式会社代表の伊達弘恭(だてひろやす)と申します。
「れあくらぼ」の「れあく」とは、Regional(地域性) Activation(活性化)の頭文字の呼び名から、「らぼ」は Laboratory(研究室)から、それぞれ由来しています。
まだ価値が見出されていない北海道の農産物と、その農産物を原料とした開発商品を世にお届けし、北海道各地域の活性化を目指している企業です。
今回のプロジェクトでは、海洋深層水から作られた自然塩「きせき」を皆さまにお届けします!
海水に含まれているマイクロプラスティックを完全除去して作った貴重な塩を、この機会にぜひお試しください。

マイクロプラスティック不検出の自然塩「きせき」
「きせき」は沖縄・久米島沖の海洋深層水で作られた自然塩です。
海洋深層水とは、通常水深200メートルより深いところにある海水を指しますが、久米島は特殊な地形をしており、水深612メートルから海水を採取することができます。
海水には、マイクロプラスティックという微細なプラスティックごみが含まれているといわれており、近年これによる海洋生態系への影響が懸念されています。
マイクロプラスティックは重みで沈んでいくため、水深が深くなるほどその含有量が多いとされています。
実際に久米島で採取した海水からも、7種類のマイクロプラスティックが検出されました。
しかし「きせき」は特殊な製法を用いることで、マイクロプラスティックの完全除去に成功!
外部の調査機関により、精製後の塩からは一切検出されないことが証明されたのです。
また、微生物の活性化実験の結果、乳酸菌の数を増やすことも実証されました。
1ccあたりの乳酸菌の数は以下のとおりです。
①きせき(満月)…約2億1千万個
②きせき(新月)…約1億3千万個
③何も添加しない…約9千万個
④一般他社の海水塩…約6千万個
手間暇をかけた、こだわりの製法
塩づくりでは通常、ろ過膜の一種である逆浸透膜を使用します。
逆浸透膜を使うと海水中の塩分濃度を一気に高めることができ、少ない時間で大量に塩を作ることができるためです。
しかし「きせき」開発者の高見氏は、この塩分濃度を高める工程でミネラルのバランスが崩れると考え、逆浸透膜を使わないことにしました。
そのため、逆浸透膜を使わず、海洋深層水をそのまま時間をかけてじっくりと煮詰める平釜製法を採用しています。海水をじっくりと煮詰めて結晶化させ、水分を飛ばして天日干しするというやり方です。
コストもかかり、一度に作れる塩の量も限られますが、質の高い塩づくりにこだわって丁寧に作っています。
新月と満月、ふたつの「きせき」
月の満ち欠けは、人体や潮の満ち引きなどさまざまなところに影響を及ぼしています。
その月の特性を活かし、「きせき」は旧暦の新月と満月の大潮のときにだけ作ります。
新月の「きせき」と満月の「きせき」。
見た目や味に違いはありませんが、人によってどちらがより合うか分かれるようです。
今回のプロジェクトのリターンでは、2種類をセットにしてお届けします。
どちらの「きせき」が合うか、ぜひご自身でお確かめください。

「きせき」の開発者である微生物研究家・高見秀弘氏のエピソードをご紹介します。
高見氏は大学卒業後、建設の仕事を経て沖縄にある微生物の研究の会社に就職しました。
そこで建築・建設の知見があったことから、微生物を建築素材に活かし、体にいい建築物を作る事業に取りかかります。
建築素材に菌を添加した空間では、されていない素材で作られた空間に比べ、有機物の腐敗が遅くなる事が実証されました。
高見氏はもっと独自の研究を進めたいと退職、独立し研究を開始します。
微生物の研究を進めて行く中で、高見氏はある事に気がつきました。
同じ微生物でも条件によって、しっかりと働く菌と、活動が緩慢な菌がある事でした。ではそれぞれに何が違うのか?
そこで高見氏は土中のミネラル量の違いに着目します。
「質の良いミネラルを与えると微生物の働きは活発化する。では質の高いミネラルとは……?質の良い……塩だ!」
そこから各地域を回り、ミネラル値の高い塩を探しますが、製造工程の簡略化や塩の品質の均一化といった事情から、塩本来のミネラルを生かしているものは皆無でした。
そんな中、ひとつだけ見つかった塩があり、その製造元とのお付き合いが始まります。
しばらくして、伊勢神宮から塩の奉納依頼が来たのです。
神事にふさわしい高品質な塩を作るため、2年かけて新設工場のための土地を探しました。
高見氏の努力が実り、久米島町にある土地を入手できることに。
しかも、塩づくりに必要な海洋深層水のパイプが下を通っている、またとない好条件です。
海水は時間が経つと劣化してしまうため、汲み上げた海水を工場の釜に直接注ぐことができるのは大きな利点でした。
長い準備期間を経て、ようやく工場が完成しました。釜の回りを囲うコンクリートには、高見氏が研究してきた技術を活かし、発酵させたコンクリートを使用しています。
現在の工場長である渡真利氏と共に試作を重ね、ついに納得できる塩が完成しました。
この時、二人は一緒に伊勢神宮に初めての奉納に参じています。当時の地元沖縄の新聞にも取り上げられました。

「きせき」のおすすめの使い方をご紹介します。毎日の食事のほか、生活のさまざまな場面でお使いいただけます。
毎日の習慣として、サプリメントのような感覚で取り入れてみてはいかがでしょうか?
コーヒーにひとつまみ
コクが増して、いつもとは違った味わいに。
スープやサラダなど、お料理の仕上げにひとつまみ
味に深みとまろやかさをプラス。
仕事の合間や運動の後にも!
バッグに入れて持ち歩き、ちょっと疲れたときにひとつまみ、といった使い方もおすすめです。
今回のクラウドファンディングでご支援いただいた資金は、CAMPFIRE手数料等ほか諸経費を除き、商品開発・製造費用の一部として大切に使わせていただきます。
スケジュールは以下のように考えております。
・2022年4月29日:プロジェクト終了
・2022年6月〜:準備が整ったリターンより、リターンを実施していきます。

以下のようなリターンをご用意しています。
・きせき《新月》《満月》セット
・きせき《新月》《満月》各3個セット
・久米島・海洋深層水自然塩「きせき」プレミアム販売権利
・久米島・海洋深層水自然塩「きせき」エグゼクティブ販売権利
詳しくは、リターン一覧をご覧ください!

「きせき」は市販の一般的な塩に比べると高価に思われるかもしれません。
しかし私たちには、「本物を世に送り出したい」という強い想いがあります。
塩や醤油、味噌など、毎日の食事に欠かせないものこそ、いいものを使ってほしい。
手軽で安価なものばかりが重宝される、世の中の風潮を変えていきたい。
そうした考えのもと、「きせき」を始めとする商品開発に取り組んでいます。
ぜひサプリメントを摂るような感覚で、日々の食生活に「きせき」を取り入れてみてください。
最後までお読みいただきありがとうございました。ご支援よろしくお願いいたします!
本プロジェクトはAll-in方式で実施します。目標金額に満たない場合も、計画を実行し、リターンをお届けします。
最新の活動報告
もっと見る
塩が高血圧の原因?
2022/04/09 18:58皆様、いつもご支援を頂き誠に有難うございます。イギリスの医学誌「ランセット」に発表された論文で、食塩の摂取量と病気の罹患率の関係を調査したものもあります。それは、男性、女性を別々に食塩摂取量の少ない順に4つのグループに分けて、様々な病気の罹患率を比べるというものです。その結果は、食塩の摂取量と高血圧には、関係性は見られませんでした。逆に心筋梗塞など心臓血管疾患による死亡率は、食塩摂取量の最も多いグループが最も低く、食塩摂取量が最も少ないグループが最も高いという結果が出ているのです。健康な25~75歳の成人で、約21万人を対象としたアメリカの「国民栄養調査」から得たデータですので、ある程度信頼しても良いのではないかと思われます。つまり「塩は悪者ではない」と現段階ではいえるのではないでしょうか。ただし大事なのは、どんな塩を選んで食べるのかということだと思います。 もっと見る
本当の塩は健康食品で、ある意味サプリかも知れませんよ!
2022/04/08 19:25皆様、いつもご支援を頂き誠に有難うございます。 昔から「うまいまずいも塩加減」と言われ、おいしい料理をつくるためには塩が重要な役割を果たしてきました。 夏の暑い盛り、スイカに塩を振りかけて食べるおいしさは、何ものにも代えがたく、生き返ったような心地がします。 では、その時に振りかける塩はなんでもいいのかというと、そうではありません。 塩は単なる調味料にとどまらず、一つの食品として私たちの健康に深く関わっているのです。 もっと見る
精製塩と海の塩は、どう違うの?
2022/04/06 22:35皆様、いつもご支援を頂き誠に有難うございます。精製塩には人間が必要とするミネラルは無い塩と思った方が宜しいでしょう。直接的に大きな危険性があるとは言えませんが、16種類の必須ミネラルと呼ばれる成分を全て含んだ海水の成分が無い精製塩を生涯摂り続けるとしたら、体のミネラルバランスが崩れる可能性があると言えるかもしれませんね。また、近年ブームとなっている減塩は更に注意する必要があります。舌で旨みを感じるべき成分が排除されているということは、その旨みを補うために化学調味料や添加物が使用されていることが非常に多いのです。また、塩分は健康な腎臓をしていれば摂り過ぎになったとしても、その分水分を欲するため自然と排出されます。塩化ナトリウムで出来ている精製塩と、ミネラルを含んだ自然な塩は、決定的な違いがあると言えます。早期に危険はないですが、徐々に体内のバランスが崩れていく可能性がある精製塩は使い続けて良いものか考える必要があるかもしれません。 もっと見る

コメント
もっと見る